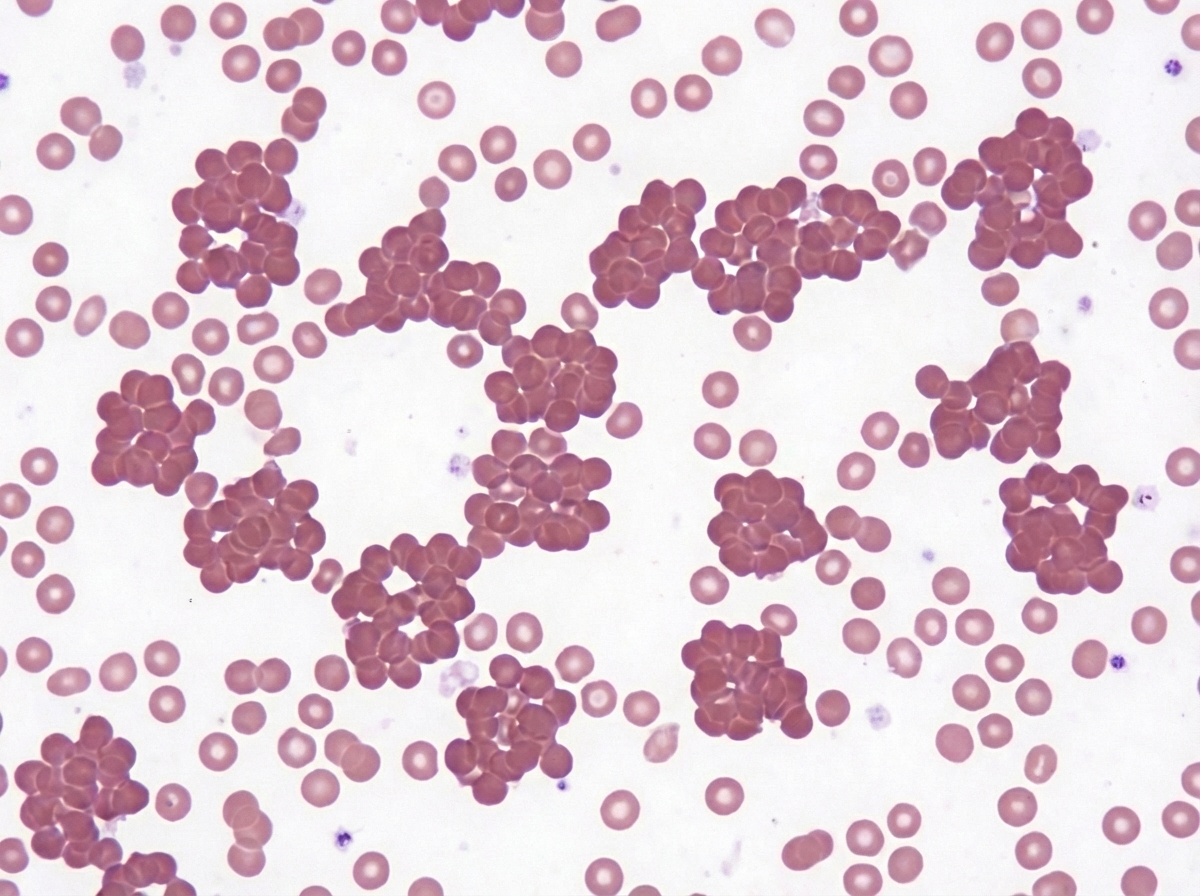
Image for question 86

Aplastic anemia is seen in all of the following conditions EXCEPT?
Which immunohistochemical marker is most useful in differentiating thymoma from acute lymphoblastic leukemia (ALL)?
A 6-year-old Afroamerican boy presented with abdominal pain, chronic hemolysis, and abnormal RBC shape on peripheral smear. What is the most likely underlying molecular disorder responsible for this condition?
Which of the following is not a B cell lymphoma?
Down syndrome predisposes to which type of cancer?
The peripheral blood smear shown in the image is most suggestive of which of the following conditions?
Which virus is most commonly associated with Burkitt's lymphoma?
Which of the following can cause eosinophilia?
Peripheral blood smear examination of a post-splenectomy patient would show the presence of which of the following?
What is the most common mutation in hemophilia?
Explanation: Aaplastic anemia is a bone marrow failure syndrome characterized by pancytopenia and a hypocellular marrow. The correct answer is **Hepatitis A infection** because, while "Post-hepatitis aplastic anemia" is a recognized clinical entity, it is most commonly associated with **Non-A, Non-B, Non-C, Non-G hepatitis viruses** (seronegative hepatitis). Hepatitis A, B, and C are extremely rare causes of aplastic anemia [1]. **Analysis of Options:** * **Paroxysmal Nocturnal Hemoglobinuria (PNH):** There is a strong pathophysiological link between PNH and aplastic anemia [4]. Many patients with aplastic anemia develop a PNH clone (due to PIGA gene mutation), and vice versa, as both involve immune-mediated stem cell destruction [1]. * **Chloramphenicol therapy:** This is a classic pharmacological cause. It can cause dose-related reversible marrow suppression or, more severely, an idiosyncratic, dose-independent irreversible aplastic anemia [1]. * **Human Immunodeficiency Virus (HIV):** HIV can cause pancytopenia through direct infection of marrow stromal cells, opportunistic infections (like CMV or Mycobacteria), or as a side effect of antiretroviral therapy (e.g., Zidovudine). **NEET-PG High-Yield Pearls:** * **Most common cause:** Idiopathic (immune-mediated T-cell destruction of stem cells) [2]. * **Most common virus:** Non-A, Non-B, Non-C hepatitis (Seronegative). * **Drug of choice:** For patients <40 years, Bone Marrow Transplant; for >40 years or no donor, Immunosuppressive therapy (Antithymocyte globulin + Cyclosporine) [2]. * **Gold Standard Diagnosis:** Bone marrow biopsy showing "dry tap" and replacement of hematopoiesis by fat cells (fatty marrow) [3]. **References:** [1] Cross SS. Underwood's Pathology: A Clinical Approach. 6th ed. Common Clinical Problems From Blood And Bone Marrow Disease, pp. 595-596. [2] Kumar V, Abbas AK, et al.. Robbins and Cotran Pathologic Basis of Disease. 9th ed. Red Blood Cell and Bleeding Disorders, p. 662. [3] Kumar V, Abbas AK, et al.. Robbins and Cotran Pathologic Basis of Disease. 9th ed. Red Blood Cell and Bleeding Disorders, pp. 662-663. [4] Cross SS. Underwood's Pathology: A Clinical Approach. 6th ed. Common Clinical Problems From Blood And Bone Marrow Disease, pp. 601-602.
Explanation: **Explanation:** The primary histological challenge in diagnosing a mediastinal mass is distinguishing between **Thymoma** (an epithelial neoplasm) [2] and **T-cell Acute Lymphoblastic Leukemia/Lymphoma (T-ALL)** [1]. 1. **Why Cytokeratin is correct:** Thymoma is a tumor derived from the **thymic epithelial cells** [2]. Cytokeratin is an intermediate filament found in epithelial cells. In a thymoma, even though there is a dense population of non-neoplastic T-lymphocytes (thymocytes), the underlying neoplastic framework consists of epithelial cells which will stain strongly positive for **Cytokeratin** [3]. In contrast, ALL is a lymphoid malignancy and will always be Cytokeratin negative [4]. 2. **Why other options are incorrect:** * **CD1a, CD3, and TdT:** These are markers for immature T-lymphocytes (thymocytes). Because thymomas are often "lymphocyte-rich," they contain numerous immature T-cells that express CD1a, CD3, and TdT. Since T-ALL also expresses these markers, they **cannot** be used to reliably differentiate between the two conditions [1]. **NEET-PG High-Yield Pearls:** * **Thymoma:** Associated with Myasthenia Gravis, Pure Red Cell Aplasia, and Hypogammaglobulinemia (Good Syndrome) [3]. * **Hassall’s Corpuscles:** These are diagnostic epithelial structures found in the medulla of the thymus [3]. * **Mediastinal Mass Differential:** Always consider the "4 Ts": Thymoma, Teratoma, Thyroid (retrosternal goiter), and "Terrible" Lymphoma [2]. * **IHC Rule:** If the question asks for an epithelial vs. lymphoid origin, **Cytokeratin** (epithelial) vs. **CD45/LCA** (lymphoid) is the most definitive discriminatory pair [4]. **References:** [1] Kumar V, Abbas AK, et al.. Robbins and Cotran Pathologic Basis of Disease. 9th ed. Diseases of White Blood Cells, Lymph Nodes, Spleen, and Thymus, pp. 599-600. [2] Cross SS. Underwood's Pathology: A Clinical Approach. 6th ed. Common Clinical Problems From Diseases Of The Urinary And Male Genital Tracts, pp. 571-572. [3] Kumar V, Abbas AK, et al.. Robbins and Cotran Pathologic Basis of Disease. 9th ed. Diseases of White Blood Cells, Lymph Nodes, Spleen, and Thymus, p. 634. [4] Cross SS. Underwood's Pathology: A Clinical Approach. 6th ed. (Basic Pathology) introduces the student to key general principles of pathology, both as a medical science and as a clinical activity with a vital role in patient care. Part 2 (Disease Mechanisms) provides fundamental knowledge about the cellular and molecular processes involved in diseases, providing the rationale for their treatment. Part 3 (Systematic Pathology) deals in detail with specific diseases, with emphasis on the clinically important aspects., pp. 208-209.
Explanation: ### Explanation The clinical presentation of a young African American child with **chronic hemolysis**, **abdominal pain** (likely due to vaso-occlusive crises or splenic sequestration), and **abnormal RBC morphology** (sickle cells) is diagnostic of **Sickle Cell Anemia (SCA)** [1], [2]. **1. Why "Point Mutation" is Correct:** Sickle Cell Anemia is caused by a specific **missense point mutation** in the $\beta$-globin gene located on chromosome 11. Specifically, there is a substitution of **Adenine by Thymine (GAG $\rightarrow$ GTG)**. This results in the replacement of the amino acid **Glutamic acid** (polar/hydrophilic) with **Valine** (non-polar/hydrophobic) at the **6th position** of the $\beta$-globin chain [1]. This single amino acid change causes Hemoglobin S (HbS) to polymerize under deoxygenated conditions, leading to the characteristic "sickling" of erythrocytes [2]. **2. Why Incorrect Options are Wrong:** * **Trinucleotide repeat:** This is the mechanism for "Anticipation" seen in neurological disorders like Huntington’s disease or Fragile X syndrome, not hemoglobinopathies. * **Antibody against RBC membrane:** This describes **Autoimmune Hemolytic Anemia (AIHA)** [2]. While it causes hemolysis, it is an acquired immune-mediated process, not a molecular genetic disorder, and typically presents with spherocytes. * **Genomic imprinting:** This involves epigenetic silencing of genes (e.g., Prader-Willi or Angelman syndromes) and does not play a role in the inheritance of structural hemoglobin variants. **High-Yield Clinical Pearls for NEET-PG:** * **Inheritance:** Autosomal Recessive [2]. * **Protective Effect:** Heterozygotes (Sickle cell trait) are protected against *Plasmodium falciparum* malaria. * **Diagnosis:** **Hb Electrophoresis** is the gold standard (HbS moves slower than HbA toward the anode). * **Complications:** Autosplenectomy (by age 6-8), Howell-Jolly bodies on smear, and increased risk of *Salmonella* osteomyelitis [3]. **References:** [1] Cross SS. Underwood's Pathology: A Clinical Approach. 6th ed. Common Clinical Problems From Blood And Bone Marrow Disease, pp. 598-599. [2] Kumar V, Abbas AK, et al.. Robbins and Cotran Pathologic Basis of Disease. 9th ed. Red Blood Cell and Bleeding Disorders, pp. 652-654. [3] Kumar V, Abbas AK, et al.. Robbins and Cotran Pathologic Basis of Disease. 9th ed. Red Blood Cell and Bleeding Disorders, pp. 645-646.
Explanation: **Explanation:** The correct answer is **Mycosis fungoides** because it is a **T-cell lymphoma**, specifically a Cutaneous T-Cell Lymphoma (CTCL) derived from mature CD4+ helper T cells [1]. **1. Why Mycosis Fungoides is the correct answer:** Mycosis fungoides is the most common primary cutaneous T-cell lymphoma [2]. It typically presents in older adults and progresses through three clinical stages: Patch, Plaque, and Tumor [1]. Histologically, it is characterized by **Pautrier’s microabscesses** (clusters of malignant T cells in the epidermis) [2] and "cerebriform" nuclei [1]. **2. Analysis of Incorrect Options (B-cell Lymphomas):** * **CLL (Chronic Lymphocytic Leukemia):** A neoplasm of mature B cells (CD5+, CD19+, CD23+). It is identical to Small Lymphocytic Lymphoma (SLL), differing only in the degree of peripheral blood involvement. * **Hairy Cell Leukemia:** A rare B-cell neoplasm characterized by "hairy" cytoplasmic projections. It is positive for B-cell markers and specific markers like **CD103, CD11c, and Annexin A1**. It is associated with the **BRAF V600E** mutation. * **Mantle Cell Lymphoma:** A B-cell lymphoma (CD5+, CD19+, Cyclin D1+) arising from the mantle zone of lymph nodes. It is characterized by the **t(11;14)** translocation, leading to overexpression of Cyclin D1. **High-Yield NEET-PG Pearls:** * **Sezary Syndrome:** The leukemic phase of Mycosis fungoides, characterized by erythroderma, lymphadenopathy, and circulating malignant T cells (Sezary cells) [1]. * **CD5 Paradox:** Both CLL and Mantle Cell Lymphoma are B-cell lymphomas that express CD5 (normally a T-cell marker). To differentiate: CLL is **CD23 positive**, while Mantle Cell is **CD23 negative**. * **TRAP Stain:** Historically used for Hairy Cell Leukemia, though Annexin A1 is now the most specific marker. **References:** [1] Kumar V, Abbas AK, et al.. Robbins and Cotran Pathologic Basis of Disease. 9th ed. Diseases of White Blood Cells, Lymph Nodes, Spleen, and Thymus, pp. 613-614. [2] Cross SS. Underwood's Pathology: A Clinical Approach. 6th ed. Common Clinical Problems From Diseases Of The Urinary And Male Genital Tracts, pp. 564-565.
Explanation: Children with Down syndrome (Trisomy 21) have a significantly increased risk (10–20 fold) of developing acute leukemias due to genetic instability and mutations in the **GATA1 gene**. **Why Acute Myeloid Leukemia (AML) is the correct answer:** While Down syndrome is associated with both ALL and AML, the association with **AML (specifically the M7 subtype: Acute Megakaryoblastic Leukemia)** is highly characteristic and unique. In children under the age of 3, AML is more common than ALL in Down syndrome patients. Many of these cases are preceded by **Transient Myeloproliferative Disorder (TMD)**, a self-limiting "leukemoid" condition seen in neonates with Trisomy 21. **Analysis of Incorrect Options:** * **B. Chronic Myeloid Leukemia (CML):** CML is characterized by the Philadelphia chromosome $t(9;22)$ [1]. There is no established clinical correlation between Down syndrome and an increased incidence of CML. * **C. Acute Lymphoblastic Leukemia (ALL):** While Down syndrome patients *do* have an increased risk of ALL (it is actually the most common leukemia in Down syndrome patients **over** the age of 3), in the context of standard medical examinations, the association with the rare M7 subtype of AML is considered the more specific "high-yield" link. * **D. Chronic Lymphocytic Leukemia (CLL):** CLL is a disease of the elderly and has no genetic or clinical association with Trisomy 21. **High-Yield Clinical Pearls for NEET-PG:** * **Age Factor:** If the patient is **<3 years old**, think **AML (M7)**. If the patient is **>3 years old**, think **ALL**. * **GATA1 Mutation:** This mutation is pathognomonic for Down syndrome-related TMD and AMKL (M7). * **Prognosis:** Interestingly, children with Down syndrome and AML (M7) often have a *better* response to chemotherapy (specifically Cytarabine) than non-Down syndrome patients. **References:** [1] Cross SS. Underwood's Pathology: A Clinical Approach. 6th ed. Common Clinical Problems From Blood And Bone Marrow Disease, pp. 605-607.
Explanation: ***Multiple myeloma*** - **Rouleaux formation** (red blood cells stacked like coins) is the hallmark finding on peripheral blood smear, caused by increased plasma proteins. - Associated with **hypercalcemia**, **bone lesions**, and **monoclonal protein** (M-spike) on serum electrophoresis. *Hodgkin's lymphoma* - Diagnosis requires identification of **Reed-Sternberg cells** on lymph node biopsy, not peripheral blood smear findings. - Peripheral blood smear typically shows **reactive lymphocytes** and **eosinophilia**, but not rouleaux formation. *Burkitt's lymphoma* - Characterized by **starry-sky pattern** on tissue biopsy with **tingible body macrophages** scattered among malignant B-cells. - Peripheral blood smear may show **blast cells** but lacks the characteristic rouleaux formation seen in multiple myeloma. *Leukemia* - Peripheral blood smear typically shows increased **blast cells** (immature white blood cells) rather than rouleaux formation. - Associated findings include **thrombocytopenia**, **anemia**, and **leukocytosis** with abnormal cell morphology.
Explanation: **Explanation:** **Burkitt’s Lymphoma (BL)** is a highly aggressive B-cell non-Hodgkin lymphoma characterized by the translocation of the **c-MYC gene** (typically t(8;14)). The **Epstein-Barr Virus (EBV)** is the primary etiological agent associated with this malignancy [1], [2]. EBV infects B-cells via the CD21 receptor, leading to immortalization and polyclonal proliferation, which increases the likelihood of a c-MYC translocation. While the association is nearly 100% in the **Endemic (African) variant** [2], it is also seen in approximately 20-30% of Sporadic cases and 25-40% of HIV-associated cases [5]. **Analysis of Incorrect Options:** * **HHV:** Specifically, HHV-8 is associated with Kaposi Sarcoma and Primary Effusion Lymphoma, not Burkitt’s [1]. * **HIV:** While HIV patients have a higher risk of developing Burkitt’s Lymphoma due to immunosuppression, the virus itself does not transform the B-cells; EBV is usually the co-factor driving the oncogenesis in these patients [4], [5]. * **HTLV:** HTLV-1 is specifically associated with **Adult T-cell Leukemia/Lymphoma (ATLL)**, which presents with "flower cells" and lytic bone lesions [1]. **High-Yield Clinical Pearls for NEET-PG:** * **Morphology:** Characterized by a **"Starry-sky appearance"** (tingible body macrophages acting as "stars" against a sea of dark neoplastic B-cells) [3]. * **Cytogenetics:** Most common translocation is **t(8;14)**; others include t(2;8) and t(8;22). * **Variants:** Endemic (jaw involvement), Sporadic (ileocecal/abdominal involvement), and Immunodeficiency-associated [2], [5]. * **Markers:** CD19, CD20, CD10, and **BCL-6 positive**; notably **BCL-2 negative**. Ki-67 index is typically ~100%. **References:** [1] Cross SS. Underwood's Pathology: A Clinical Approach. 6th ed. (Basic Pathology) introduces the student to key general principles of pathology, both as a medical science and as a clinical activity with a vital role in patient care. Part 2 (Disease Mechanisms) provides fundamental knowledge about the cellular and molecular processes involved in diseases, providing the rationale for their treatment. Part 3 (Systematic Pathology) deals in detail with specific diseases, with emphasis on the clinically important aspects., pp. 219-220. [2] Kumar V, Abbas AK, et al.. Robbins and Cotran Pathologic Basis of Disease. 9th ed. Neoplasia, pp. 335-336. [3] Kumar V, Abbas AK, et al.. Robbins and Cotran Pathologic Basis of Disease. 9th ed. Diseases of White Blood Cells, Lymph Nodes, Spleen, and Thymus, p. 606. [4] Kumar V, Abbas AK, et al.. Robbins and Cotran Pathologic Basis of Disease. 9th ed. Diseases of the Immune System, pp. 262-263. [5] Kumar V, Abbas AK, et al.. Robbins and Cotran Pathologic Basis of Disease. 9th ed. Diseases of the Immune System, pp. 261-262.
Explanation: **Explanation:** The correct answer is **Miliary Tuberculosis**. While tuberculosis is typically associated with lymphocytosis or monocytosis [1,2,3], **miliary tuberculosis** (disseminated TB) is a well-recognized cause of **eosinophilia** [4]. This occurs due to the massive hematogenous spread of *Mycobacterium tuberculosis*, which triggers a systemic hypersensitivity response and granulomatous inflammation [4]. In some cases, miliary TB can also present with "leukemoid reactions" or even eosinophilic leukemoid reactions [4]. **Analysis of Options:** * **A. Hodgkin’s Disease:** While Hodgkin’s lymphoma is a classic cause of eosinophilia (mediated by IL-5 secretion from Reed-Sternberg cells) [2,3], it is not the intended answer here as miliary TB is a more specific systemic infectious cause often tested in this context. * **B. Filariasis:** Parasitic infections are the most common cause of eosinophilia globally [2,3]. However, in the context of this specific question, miliary TB is highlighted to test the student's knowledge of atypical presentations of mycobacterial infections. * **D. HIV Infection:** HIV typically causes **eosinopenia** (low eosinophil count) or lymphopenia. While advanced AIDS patients may develop eosinophilia due to secondary opportunistic infections or drug reactions, HIV itself does not cause it. **High-Yield NEET-PG Pearls:** * **Causes of Eosinophilia (NAACP):** **N**eoplasia (Hodgkin’s), **A**llergy/Asthma, **A**ddison’s disease, **C**onnective tissue disorders (Churg-Strauss), **P**arasites (Strongyloides, Filariasis) [2,3]. * **Eosinopenia:** Characteristically seen in **Cushing’s syndrome**, **ACTH administration**, and **acute bacterial infections** (stress response). * **Miliary TB** is a "great imitator" and can present with pancytopenia, leukemoid reactions, or eosinophilia [4]. **References:** [1] Cross SS. Underwood's Pathology: A Clinical Approach. 6th ed. (Basic Pathology) introduces the student to key general principles of pathology, both as a medical science and as a clinical activity with a vital role in patient care. Part 2 (Disease Mechanisms) provides fundamental knowledge about the cellular and molecular processes involved in diseases, providing the rationale for their treatment. Part 3 (Systematic Pathology) deals in detail with specific diseases, with emphasis on the clinically important aspects., pp. 195-196. [2] Kumar V, Abbas AK, et al.. Robbins and Cotran Pathologic Basis of Disease. 9th ed. Diseases of White Blood Cells, Lymph Nodes, Spleen, and Thymus, p. 592. [3] Cross SS. Underwood's Pathology: A Clinical Approach. 6th ed. Common Clinical Problems From Blood And Bone Marrow Disease, pp. 580-581. [4] Cross SS. Underwood's Pathology: A Clinical Approach. 6th ed. Common Clinical Problems From Respiratory Tract Disease, pp. 320-321.
Explanation: **Explanation:** The correct answer is **Howell-Jolly bodies**. **1. Why Howell-Jolly bodies are correct:** Howell-Jolly bodies are small, round, basophilic nuclear remnants (DNA) found within red blood cells [1]. Under normal physiological conditions, the spleen acts as a "pitting" organ; as RBCs pass through the splenic sinusoids, the splenic macrophages identify and remove these nuclear fragments. Following a **splenectomy** (or in functional asplenia like Sickle Cell Anemia), this filtering mechanism is lost, allowing RBCs with these inclusions to circulate in the peripheral blood [1], [2]. **2. Analysis of Incorrect Options:** * **A. Dohle bodies:** These are light blue, peripheral cytoplasmic inclusions in neutrophils composed of dilated rough endoplasmic reticulum. They are seen in **leukemoid reactions**, severe infections, or burns, not post-splenectomy. * **B. Hypersegmented neutrophils:** Defined as neutrophils with $\geq$ 6 lobes, these are a hallmark of **Megaloblastic anemia** (Vitamin B12 or Folate deficiency). * **C. Spherocytes:** These are small, dense RBCs lacking central pallor. They are characteristic of **Hereditary Spherocytosis** or Immune Hemolytic Anemia. While the spleen destroys spherocytes, their presence is not a specific marker of the post-splenectomy state itself. **3. NEET-PG High-Yield Pearls (Post-Splenectomy Blood Picture):** Beyond Howell-Jolly bodies, look for these findings in a post-splenectomy smear: * **Pappenheimer bodies:** Siderotic (iron) granules. * **Heinz bodies:** Denatured hemoglobin (seen with supravital stains). * **Target cells (Codocytes):** Due to an increase in the surface-area-to-volume ratio. * **Acanthocytes:** Irregularly spiked cells. * **Transient Thrombocytosis and Leucocytosis:** Occurs immediately post-surgery. **References:** [1] Kumar V, Abbas AK, et al.. Robbins and Cotran Pathologic Basis of Disease. 9th ed. Red Blood Cell and Bleeding Disorders, pp. 644-645. [2] Cross SS. Underwood's Pathology: A Clinical Approach. 6th ed. Common Clinical Problems From Blood And Bone Marrow Disease, pp. 578-579.
Explanation: **Explanation:** **Hemophilia A** is an X-linked recessive bleeding disorder caused by a deficiency or dysfunction of **Coagulation Factor VIII**. The molecular basis of this disease is highly heterogeneous, but the **Intron 22 inversion** is the most significant and frequent genetic alteration [1]. 1. **Why Intron 22 inversion is correct:** This mutation occurs due to an intrachromosomal recombination between a sequence within intron 22 of the Factor VIII gene and a homologous region located outside the gene. This "flip" disrupts the gene sequence, leading to a complete lack of functional Factor VIII protein. It is found in approximately **40–50% of cases of severe Hemophilia A**, making it the single most common mutation identified in this population [1]. 2. **Analysis of Incorrect Options:** * **Option A (Intron 1 inversion):** This is the second most common inversion in Hemophilia A, but it occurs in only about **2–5%** of severe cases. * **Option C (619 bp deletion):** This specific deletion is a classic molecular finding in **Beta-thalassemia** (specifically the Indian variety), not hemophilia [1]. * **Option D (3.7 kb deletion):** This is the most common mutation associated with **Alpha-thalassemia** (specifically $\alpha^+$-thalassemia), resulting from unequal crossing over between the $\alpha1$ and $\alpha2$ globin genes. **High-Yield Clinical Pearls for NEET-PG:** * **Hemophilia A:** Factor VIII deficiency; prolonged aPTT, normal PT, and normal bleeding time [1]. * **Hemophilia B (Christmas Disease):** Factor IX deficiency; clinically indistinguishable from Hemophilia A. * **Mixing Studies:** In Hemophilia, the prolonged aPTT **corrects** upon mixing with normal plasma (distinguishes deficiency from inhibitors). * **Severe Disease:** Defined as <1% factor activity; often presents with spontaneous hemarthrosis (bleeding into joints, most commonly the knee) [1]. **References:** [1] Kumar V, Abbas AK, et al.. Robbins and Cotran Pathologic Basis of Disease. 9th ed. Red Blood Cell and Bleeding Disorders, pp. 670-671.
Anemias: Classification and Approach
Practice Questions
Hemolytic Anemias
Practice Questions
Myeloproliferative Neoplasms
Practice Questions
Myelodysplastic Syndromes
Practice Questions
Acute Leukemias
Practice Questions
Chronic Leukemias
Practice Questions
Lymphomas and Lymphoid Neoplasms
Practice Questions
Plasma Cell Disorders
Practice Questions
Bleeding Disorders
Practice Questions
Thrombotic Disorders
Practice Questions
Get full access to all questions, explanations, and performance tracking.
Start For Free